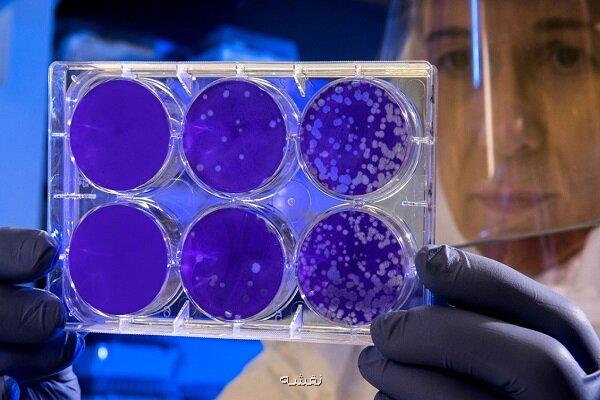
یک نانوذره معدنی شاید جایگزین آنتی بیوتیک ها شود

در مقاله ای بررسی شد؛
یک نانوذره معدنی شاید جایگزین آنتی بیوتیک ها شود
نقشه: بتازگی جزییات تولید و مشخصه یابی نانوذرات پلی فسفات کلسیم که با نقره تقویت شده، انتشار یافته است. این نانوذرات اثرات ضدباکتریایی داشته و می تواند به عنوان جایگزینی برای آنتی بیوتیک ها باشد.
به گزارش نقشه به نقل از مهر، پژوهشگران با تکامل مداوم و پیشرفت در حوزه علوم زیست پزشکی، بطور مداوم بدنبال راهکارهای نوآورانه و مؤثر برای مقابله با چالش های مختلف حوزه بهداشت هستند. یکی از این نوآوری های امیدوارکننده، استفاده از نانوذرات، خصوصاً نانوذرات پلی فسفات کلسیم تقویت شده با نقره (Ag-CaPp) برای کاربردهای زیست پزشکی است.
پژوهشگران در مقاله ای که بتازگی پخش شده، جزئیاتی درباره ی تهیه نانوذرات پلی فسفات کلسیم تقویت شده با نانوذرات نقره منتشر نمودند. پژوهشگران با تمرکز بر خصوصیات فیزیکوشیمیایی این نانوذرات، توصیف کاملی از نانوذرات آماده شده ارائه کردند. یکی از نکات جالب توجه که در این مقاله به آن اشاره شده این است که با افزایش درصد نقره، در اندازه ذرات و پایداری حرارتی نانوذرات بهبود قابل توجهی مشاهده می شود.
یکی از یافته های کلیدی این مطالعه، فعالیت ضد باکتریایی قابل توجه این نانوذرات است. بررسی های پژوهشگران نشان داد که این نانوذرات را می توان به عنوان تغییر دهنده بالقوه بازی در مبارزه با عفونت های باکتریایی متعدد، خصوصاً در بهبود زخم و عفونت های بافت استخوان استفاده نمود. علاوه بر این، نانوذرات حتی با بالاترین میزان نقره نیز، رفتار غیر سیتوتوکسیک نشان دادند، در حقیقت افزایش نقره سبب اثرات سمی روی این نانوذرات نمی شود که این مساله در بررسی از نظر ایمنی و اثربخشی در پزشکی اهمیت زیادی دارد.
بعد از آزمایش های دقیق، پژوهشگران این پروژه دریافتند که سه درصد نقره به عنوان عامل تقویت کننده در ساختار این نانوذرات می تواند غلظت بهینه برای کاربردهای زیست پزشکی باشد بطوریکه به آسانی و خیالی آسوده بتوان از آن در کارهای بالینی از آن استفاده نمود. این میزان تقویت با نقره رفتار سمی برای سلول بدنبال ندارد و به ترمیم زخم ها کمک شایانی می کند. نتایج این پروژه گامی مهم در عرصه تحقیقات زیست پزشکی است چونکه یک نانوذرات تقویت شده با نقره را معرفی می کند که پتانسیل استفاده در پزشکی را داشته و در عین حال می تواند جایگزین آنتی بیوتیک ها شود.
البته جهت استفاده از آن در کلینیک ها هنوز نیاز به تحقیقات بیشتر روی این نانوذره وجود دارد تا جوانب مختلف آن بررسی شود.
این مطلب Go Map را می پسندید؟
(1)
(0)
تازه ترین مطالب مرتبط در نقشه
نظرات بینندگان نقشه در مورد این مطلب